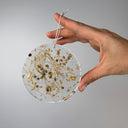
Hand holding a round decorative resin suncatcher with gold leaf plant fiber and seeds against a gray background

Hemp + Resin Ornaments / Sun Catchers
4 for $50
Hemp + Resin Ornaments / Sun Catchers - is backordered and will ship as soon as it is back in stock.
Our beautiful resin suncatchers capture the unique beauty of the many forms of the hemp plant. To give our hemp ornaments a special glow, they are all accented with gold flakes for a little sparkle. Each hangs with a small piece of hemp twine.
These ornaments feature 4 designs:
- Hemp Flower, Bast, and Seed
- Hemp Fabric, Sliver, Bast, and Seed
- Hemp Hurd, Bast, and Seed
- Hemp Cottonized Fiber, Bast, and Seed
Each 4-inch suncatcher is completely one of a kind and handcrafted to last a lifetime, in Denver by resin artist Nastassia Costache.
Whether hanging in a sunny window or adorning your seasonal tree, these conversation pieces are a reminder that hemp is worth celebrating every day, in every way.
Sold individually for $15 or add all 4 to your cart for a bundle price of $50.
Handmade in Colorado, USA

Hemp + Resin Ornaments / Sun Catchers - is backordered and will ship as soon as it is back in stock.
Specifications
Specifications
-
Key Features
-
Material
-
Design
-
Size
-
Count
-
Care Instructions

Meet the Maker
Nastassia Costache